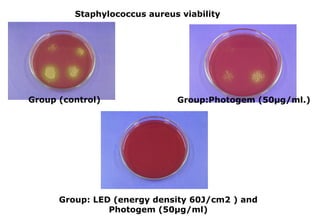
Staphylococcus aureus viability

Group (control)

Group:Photogem (50µg/ml.)

Group: LED (energy density 60J/cm2 ) and
Photogem (50µg/ml)

O documento descreve iniciativas de parcerias entre universidades e empresas para promover inovação tecnológica. Ele apresenta exemplos de projetos conjuntos em diferentes estágios, desde a geração de ideias na universidade até o desenvolvimento de produtos e spin-offs. O texto enfatiza a importância da colaboração entre os setores para aumentar a competitividade por meio da inovação.















![Modo de operação:
Veduca disponibiliza gratuitamente e sem custo a USP
Pode veicular anúncios limitados]
Fornece monitores e acompanhamento
Oferece monitores e exame presencial por curso
Cobra o exame presencial ( R$ 50 a R$ 100/ aluno)
Emissão de certificado de compatibilidade de conhecimento](https://image.slidesharecdn.com/aula4profvanderlei-140226091827-phpapp02/85/Aula-4-prof-vanderlei-16-320.jpg)